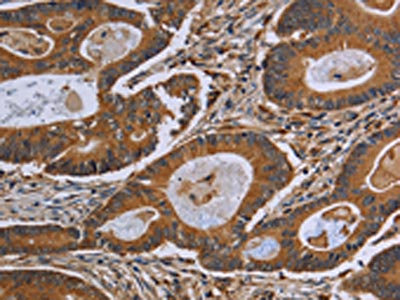

GJB4 Antibody
-
中文名稱:GJB4兔多克隆抗體
-
貨號:CSB-PA558294
-
規格:¥1100
-
圖片:
-
The image on the left is immunohistochemistry of paraffin-embedded Human thyroid cancer tissue using CSB-PA558294(GJB4 Antibody) at dilution 1/40, on the right is treated with synthetic peptide. (Original magnification: ×200)
-
The image on the left is immunohistochemistry of paraffin-embedded Human colon cancer tissue using CSB-PA558294(GJB4 Antibody) at dilution 1/40, on the right is treated with synthetic peptide. (Original magnification: ×200)
-
Gel: 10%SDS-PAGE, Lysate: 40 μg, Lane 1-2: Mouse skin tissue, Hela cells, Primary antibody: CSB-PA558294(GJB4 Antibody) at dilution 1/200, Secondary antibody: Goat anti rabbit IgG at 1/8000 dilution, Exposure time: 5 minutes
-
-
其他:
產品詳情
-
Uniprot No.:
-
基因名:GJB4
-
別名:GJB4; Gap junction beta-4 protein; Connexin-30.3; Cx30.3
-
宿主:Rabbit
-
反應種屬:Human,Mouse
-
免疫原:Synthetic peptide of Human GJB4
-
免疫原種屬:Homo sapiens (Human)
-
標記方式:Non-conjugated
-
抗體亞型:IgG
-
純化方式:Antigen affinity purification
-
濃度:It differs from different batches. Please contact us to confirm it.
-
保存緩沖液:-20°C, pH7.4 PBS, 0.05% NaN3, 40% Glycerol
-
產品提供形式:Liquid
-
應用范圍:ELISA,WB,IHC
-
推薦稀釋比:
Application Recommended Dilution ELISA 1:2000-1:5000 WB 1:500-1:2000 IHC 1:50-1:200 -
Protocols:
-
儲存條件:Upon receipt, store at -20°C or -80°C. Avoid repeated freeze.
-
貨期:Basically, we can dispatch the products out in 1-3 working days after receiving your orders. Delivery time maybe differs from different purchasing way or location, please kindly consult your local distributors for specific delivery time.
-
用途:For Research Use Only. Not for use in diagnostic or therapeutic procedures.
相關產品
靶點詳情
-
功能:Structural component of gap junctions. Gap junctions are dodecameric channels that connect the cytoplasm of adjoining cells. They are formed by the docking of two hexameric hemichannels, one from each cell membrane. Small molecules and ions diffuse from one cell to a neighboring cell via the central pore.
-
基因功能參考文獻:
- GJB4 may be a genetic risk factor for the development of nonsyndromic hearing loss and the data from the present study can be used to direct the clinical evaluation and effectively manage the care of families of children with GJB4. PMID: 25333454
- In this study, we found no mutations of GJB4 in two Progressive symmetrical erythrokeratoderma families. PMID: 23678955
- Letter: describe erythrokeratodermia variabilis phenotype related to novel mutation in GJB4 gene. PMID: 23037955
- Mutation analysis of GJB3 and GJB4 in Chinese patients with erythrokeratodermia variabilis. PMID: 21950330
- Bidirectional sequencing of the coding region of GJB4 revealed a novel c.295G>A missense mutation. PMID: 22266302
- There were no mutations found in the GJB4 gene and the true pathogenesis of progressive symmetrical erythrokeratodermia remains unknown. PMID: 21198793
- A common frameshift mutation and other variants in GJB4 (connexin 30.3): Analysis of hearing impairment families PMID: 11933201
- the involvement of connexin gene 30.3 (GJB4) in the etiology of erythrokeratodermia variabilis PMID: 12648223
- These results not only provide new insights into epidermal connexin synthesis and polymerization, but also allow a novel molecular explanation for the similarity of EKV phenotypes. PMID: 14583444
- Not all clinically diagnosed individuals with erythrokeratoderma variabilis harbor Cx30.3 disease-associated mutations. PMID: 16297190
- Five patients with erythrokeratodermia variabilis of Mendes da Costa and progressive symmetric erythrokeratodermia of Gottron had the same mutation in the GJB4 gene causing the amino acid substitution p.Gly12Asp (G12D). PMID: 19291775
顯示更多
收起更多
-
相關疾病:Erythrokeratodermia variabilis et progressiva 2 (EKVP2)
-
亞細胞定位:Cell membrane; Multi-pass membrane protein. Cell junction, gap junction.
-
蛋白家族:Connexin family, Beta-type (group I) subfamily
-
數據庫鏈接:
Most popular with customers
-
-
YWHAB Recombinant Monoclonal Antibody
Applications: ELISA, WB, IHC, IF, FC
Species Reactivity: Human, Mouse, Rat
-
Phospho-YAP1 (S127) Recombinant Monoclonal Antibody
Applications: ELISA, WB, IHC
Species Reactivity: Human
-
-
-
-
-